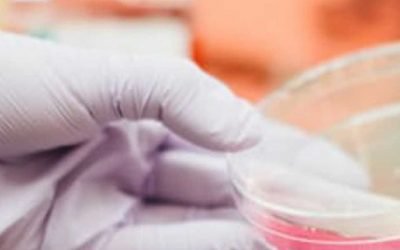
Διαχείριση Κρύας Αλυσίδας: Ένα Κρίσιμο Σημείο για τα Ευαίσθητα στη Θερμοκρασία Φάρμακα Κλινικών Δοκιμών

Σύντομο Ιστορικό της Sensitech: Παρακολούθηση της Κρύας Αλυσίδας 3.0 Η Παγκόσμια Επέκταση Δημιουργεί Νέες Ευκαιρίες και Προκλήσεις Corporate Food Life Sciences Στις 22 Ιουνίου 2020, η Sensitech® θα γιορτάσει την επέτειο των 30 χρόνων ως κορυφαίος πάροχος λύσεων...
Άρθρα
Ενημέρωση | Έρευνα | Τεχνολογία
Λύσεις Sensitech: Παίζουν Σημαντικό Ρόλο στην Κρίση
Λύσεις Sensitech: Παίζουν Σημαντικό Ρόλο στην Κρίση Η σημασία της παρακολούθησης φορτίου για τη διαχείριση της ψυχρής αλυσίδας Εταιρική εφοδιαστική αλυσίδα Επιστημών Ζωής Λύσεις Sensitech: Ενώ η Sensitech® κατέρριψε το ρεκόρ παρακολούθησης 15 εκατομμυρίων αποστολών...
Διαχείριση Κρύας Αλυσίδας: Ένα Κρίσιμο Σημείο για τα Ευαίσθητα στη Θερμοκρασία Φάρμακα Κλινικών Δοκιμών
Διαχείριση Κρύας Αλυσίδας: Ένα Κρίσιμο Σημείο για τα Ευαίσθητα στη Θερμοκρασία Φάρμακα Κλινικών Δοκιμών Life Sciences Η επιβάρυνση εμφάνισης ασθενειών, η αύξηση του γηράσκοντος πληθυσμού και η μείωση του αγωγού προϊόντων των παλαιοτέρων συχνά συνταγογραφούμενων...
Θερμική Χαρτογράφηση
Θερμική Χαρτογράφηση Η Θερμική Χαρτογράφηση πραγματοποιείται για να προσδιοριστεί εάν μια περιοχή αποθήκευσης (ψυγεία, καταψύκτες, δωμάτια, αποθήκες και εκκολαπτήρια κλπ.), μπορεί να διατηρήσει τη θερμοκρασία μέσα σε καθορισμένα όρια. Οι αισθητήρες διανέμονται σε όλη...
Τα οφέλη και οι κίνδυνοι της διαλειτουργικότητας των Dataloggers / Καταγραφικών Δεδομένων και η Απελευθέρωση Δεδομένων Προϊόντων
Τα οφέλη και οι κίνδυνοι της διαλειτουργικότητας των Dataloggers / Καταγραφικών Δεδομένων και η Απελευθέρωση Δεδομένων Προϊόντων Τα ακόλουθα είναι απόσπασμα από την πλήρη αναφορά της Sensitech με τίτλο: Digital Transformation of the Cold Chain: Introducing...
Δείκτες Θερμοκρασίας Χρόνου & Έξυπνη Συσκευασία
Δείκτες Θερμοκρασίας Χρόνου & Έξυπνη Συσκευασία Οι Δείκτες Θερμοκρασίας Χρόνου είναι οι συσκευές που παίζουν σημαντικό ρόλο στην ποιότητα και ασφάλεια των ευαίσθητων προϊόντων. Η θερμοκρασία είναι ο ένας από τους κρίσιμους παράγοντες για την ποιότητα και την...
Οικοδομώντας μια Βιώσιμη Εφοδιαστική Αλυσίδα
Οικοδομώντας μια Βιώσιμη Εφοδιαστική Αλυσίδα Οικοδομώντας μια Βιώσιμη Εφοδιαστική Αλυσίδα Για σχεδόν 30 χρόνια, η Sensitech® Inc., βοήθησε κορυφαίες εταιρείες σε τρόφιμα, φαρμακευτικά, βιομηχανικά και τα καταναλωτικά αγαθά, προστατεύοντας τα προϊόντα τους – και το...
Κρύα Αλυσίδα και η Διαχείριση της
Κρύα Αλυσίδα και η Διαχείριση της Η Κρύα Αλυσίδα αναφέρεται στο σύνολο της εφοδιαστικής αλυσίδας και περιλαμβάνει την παραγωγή, την αποθήκευση και την διανομή προϊόντων που χρειάζονται ορισμένα επίπεδα ελέγχου θερμοκρασίας για να διατηρήσουν τα χαρακτηριστικά τους και...
Επιλογή Καταγραφικού Θερμοκρασίας
Επιλογή Καταγραφικού Θερμοκρασίας Επιλογή Καταγραφικού Θερμοκρασίας Τα καταγραφικά δεδομένων χρησιμοποιούνται ευρέως από εργολάβους, τεχνικούς υπηρεσιών και μηχανικούς που είναι υπεύθυνοι για την παρακολούθηση εσωτερικών περιβαλλοντικών συνθηκών, για την διερεύνηση...
Πώς οι Οδηγίες της ΕΕ για το ΑΕγχΠ επηρεάζουν την Κρύα Αλυσίδα Φαρμακευτικών Προϊόντων
Πώς οι Οδηγίες της ΕΕ για το ΑΕγχΠ επηρεάζουν την Κρύα Αλυσίδα Φαρμακευτικών Προϊόντων Πώς οι Οδηγίες της ΕΕ για το ΑΕγχΠ επηρεάζουν την Κρύα Αλυσίδα Φαρμακευτικών Προϊόντων:Οι Ευρωπαϊκές Οδηγίες σχετικά με τις ορθές πρακτικές παρασκευής και διανομής αποσκοπούν στο να...
ΣΧΕΤΙΚΑ ΜΕ ΤΑ ΠΡΟΙΟΝΤΑ
Η Sensitech Λανσάρει Εφαρμογή-Ενεργοποιημένη, Ανέγγιχτη, Λύση Παρακολούθησης Θερμοκρασίας για Ενισχυμένη Ορατότητα στην Εφοδιαστική Αλυσίδα
Δήλωση του Henry Ames (Γενικός Διευθυντής Life Sciences, της Sensitech). Διαβάστε τη δήλωση…
21-CN-02 / Γνωστοποίηση Αλλαγών
O Eλάχιστος Χρόνος Καταγραφής για τους δείκτες VaxAlert & VaxAlert USB, άλλαξε από 20 σε 40 ημέρες
Διαβάστε την Γνωστοποίηση Αλλαγών
2018 IATA/ICAO Dangerous Goods Regulations – Lithium Metal Batteries
Αφορά τις μεταλλικές μπαταρίες των προϊόντων της Sensitech, σύμφωνα με τον κανονισμό 2018 IATA/ICAO που αφορά τα επικίνδυνα προϊόντα – Μεταλλικές Μπαταρίες Λιθίου. Περισσότερα…
TLS 1.0 Industry “End of Life” for Continued Use of ColdStream® Services
H Sensitech Inc., παίρνει πολύ σοβαρά την ασφάλεια των δεδομένων των πελατών της. Η λύση ColdStream® CCM – για την οποία απαιτείται σύνδεση με το διαδίκτυο – παρέχει τα κατάλληλα πρότυπα. Το πρότυπο Transport Layer Security (TLS), είναι κρυπτογραφημένο πρωτόκολλο για την ασφαλή επικοινωνία και την ακεραιότητα των δεδομένων. Περισσότερα…
Πού Είναι το Φορτίο μου Τώρα;
Χρησιμοποιήστε την παρακολούθηση με βάση τον αισθητήρα για να εξαλείψετε τα κενά αποστολής φορτίου και τα τυφλά σημεία στην εφοδιαστική σας αλυσίδα.
ΞΕΝΟΣ ΤΥΠΟΣ
Real-time temp loggers tell the story / By Glenn Hale, John Lopresti and Dario Stefanelli
Ως μέρος δοκιμών της παρακολούθησης της θερμοκρασίας για το SSC project, η Agriculture Victoria πρόσφατα παρακολούθησαν ένα ναύλο εμπορικού φορτίου από την Αυστραλία στην Κίνα χρησιμοποιώντας ένα καταγραφικό θερμοκρασίας Sensitech TempTale® GEO Eagle. Περισσότερα…
Time- and Temperature-Controlled Transport: Supply Chain Challenges and Solutions / by Claire Sykes
Σε ολόκληρο τον πλανήτη, τα φαρμακευτικά προϊόντα αξίας δισεκατομμυρίων δολαρίων αποθηκεύονται και αποστέλλονται σε ακατάλληλες θερμοκρασίες ή καθυστερούν, φτάνοντας με μειωμένη διάρκεια ζωής στο ράφι. Το άρθρο αυτό, εξηγεί τις προκλήσεις και τις λύσεις στην αλυσίδα εφοδιασμού για την διατήρηση ορθών πρακτικών διανομής. Περισσότερα…
Sensitech Inc. Marks 30th Anniversary and Introduces New SensiWatch™ Platform for End-to-End Real-Time In-Transit Visibility
Η Sensitech Inc. γιορτάζει την 30ή επέτειο και παρουσιάζει τη νέα πλατφόρμα SensiWatchTM για ορατότητα από άκρο σε άκρο σε πραγματικό χρόνο κατά τη μεταφορά των εμπορευμάτων.Για 30 χρόνια, η Sensitech Inc. συμβάλλει στην ηγεσία εταιρείες στον κλάδο των τροφίμων, φαρμακευτικών, βιομηχανικών και καταναλωτικών αγαθών.
ΝΕΑ ΜΟΝΤΕΛΑ
Ενημερωθείτε για ότι νεώτερο κυκλοφορεί σχετικά με τον δικό σας κλάδο
TempTale® Ultra BLE – είναι καταγραφικό θερμοκρασίας επόμενης γενιάς — της οικογένειας TempTale Ultra — δίνει τη δυνατότητα ελέγχου θερμοκρασίας χωρίς άγγιγμα των αποστολών του τελευταίου μιλίου Life Sciences κατά τη μεταφορά. Να είστε σίγουροι ότι τα ευαίσθητα στη θερμοκρασία προϊόντα σας αποθηκεύονται, αποστέλλονται και παραλαμβάνονται στο ιδανικό εύρος θερμοκρασίας ή αναγνωρίζετε εύκολα εάν οι θερμοκρασίες έχουν υπερβεί τα όρια συναγερμού. Ο λεπτός σχεδιασμός ταιριάζει σε μικρότερες συσκευασίες, καθιστώντας το TempTale Ultra BLE ιδανικό για κλινικά κιτ, εργαστηριακές και βιολογικές αποστολές και τελευταίο μίλι απευθείας σε ασθενείς, φαρμακεία, νοσοκομεία και ιατρεία. Περισσότερα…
ΚΑΙΝΟΤΟΜΙΑ
Η σημερινή αλυσίδα εφοδιασμού είναι παγκόσμια, όπως και η Sensitech.
Ως ηγέτης στην ορατότητα της εφοδιαστικής αλυσίδας, παρέχουμε καινοτόμες λύσεις για τη διατήρηση της ποιότητας, της ακεραιότητας και της ασφάλειας πολύτιμων φορτίων σε κάθε στάδιο του ταξιδιού, σε όλο τον κόσμο.
Χρήση των IoT Data για τη Βελτίωση Ποιότητας στην Εφοδιαστική Αλυσίδα
8 Πραγματικές Περιπτώσεις Χρήσης στην Βιομηχανία Τροφίμων.
Η διατήρηση του υψηλότερου δυνατού επιπέδου ποιότητας προϊόντος σε όλη την αλυσίδα εφοδιασμού είναι η βασική απαίτηση για τον έλεγχο της συμμόρφωσης, της κερδοφορίας και της ικανοποίησης των καταναλωτών.